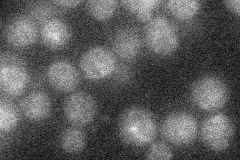
YMR019W
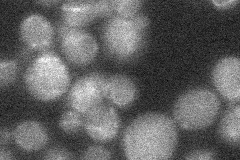
YMR019W
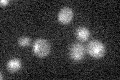
YMR019W

View description
Protein that binds Sin3p in a two-hybrid assay; contains a Zn(II)2Cys6 zinc finger domain characteristic of DNA-binding proteins; computational analysis suggests a role in regulation of expression of genes encoding transporters
Localization:
Intensity:
Fold change:
Significance:
-
C’ GFP library in SD

nucleus20.99 -
N' NOP1pr-GFP in SD
ambiguous18.9964 -
N' TEF2pr-mCherry in SD

below threshold5.14395 -
N' NATIVEpr-GFP in SD
below threshold18.6632 -
N' TEF2pr-VC and Cyto-VN in SD

#N/A0 -
C’ GFP library in SD+DTT

nucleus18.430.87No -
C’ GFP library in SD+H2O2

nucleus21.151No -
C’ GFP library in Starvation Media
nucleus17.410.82Yes -
C’ GFP library on the background of Pup2-DaMP

nucleus -
C’ GFP library on the background of CCT mutant

nucleus21.47571.02273No
